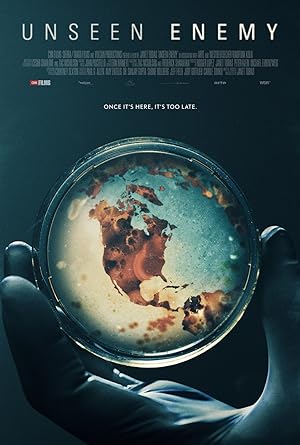
Cover image of the movie Unseen Enemy (2017)

Unseen Enemy (2017) Subtitles
- Genre(s) : Documentary
- Country: United States, Brazil, Cambodia, China, Congo, Germany, Liberia, Sierra Leone, Singapore, Switzerland, Thailand, United Kingdom
- Release year: 2017
- Duration: 1h 37m
- Director(s): Janet Tobias
- Actors(s): Larry Brilliant, John Connor, Decontee Davis
- Trailer : Watch
-
Synopsis:
Unseen Enemy is a feature-length documentary about the threat of epidemics in the 21st century and what we can do to fight them.